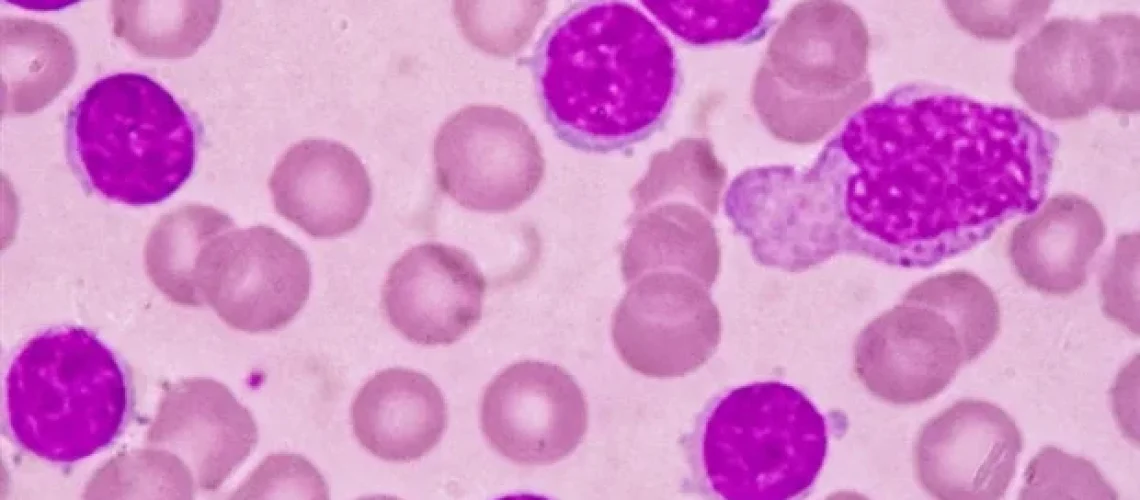
טיפול משך זמן קבוע פועל ביעילות כמו טיפול מתמשך בלוקמיה לימפוציטית כרונית

על פי ניסוי חדש, חולים עם לוקמיה לימפוציטית כרונית (CLL) מראים תוצאות דומות בין אם הם מקבלים טיפול חד-פעמי ללא הגבלת זמן או טיפול משולב לפרק זמן קבוע.
המחקר הוא הניסוי הפרוספקטיבי הראשון שמשוווה ישירות בין שתי הגישות הללו. עם מעקב חציוני של כמעט שלוש שנים, התוצאות מראות שגישות אלו מקבילות במהותן מבחינת הסיכון למוות או התקדמות המחלה.
כרופאים, לעתים קרובות אנו מניחים שטיפול מתמשך תמיד יהיה יעיל יותר כי אתה פשוט נותן יותר טיפול, אבל המחקר הזה מראה שזה לא בהכרח המקרה. התוצאות מספקות את ההוכחה הראשונה לכך שטיפול משך זמן קבוע, אותו מטופלים מעדיפים לעתים קרובות, אכן אינו נחות מטיפול מתמשך, דבר המצביע על יעילות שווה מבחינה קלינית".
עותמאן אל סוואף, MD, מחבר המחקר הראשי, המטולוג ואונקולוג רפואי, אוניברסיטת קלן, גרמניה
CLL היא הלוקמיה המבוגרת השכיחה ביותר שבה תאי דם לבנים לא תקינים גדלים ללא שליטה ומצטברים במח העצם פותחו שלוש קבוצות של חומרים המכוונים ל-CLL: מעכבי ברוטון טירוזין קינאז (BTK), מעכבי BCL2 ונוגדנים CD20. משטרי טיפול מומלצים עבור CLL שאובחן לאחרונה מתחלקים לשתי קטגוריות עיקריות: טיפול מתמשך בלתי מוגבל עם מעכב BTK או טיפול קבוע, הנמשך בדרך כלל כשנה, תוך שימוש בשילוב של מעכב BCL2 ונוגדן CD20 או מעכב BTK.
כדי להשוות גישות אלו, החוקרים הקצו באופן אקראי 909 חולים מבוגרים לאחד משלושה משטרי טיפול. אלה שהוקצו לזרוע "I" קיבלו איברוטיניב מתמשך (מעכב BTK) ללא הגבלת זמן, אלא אם כן הם חוו התקדמות המחלה או תופעות לוואי בלתי מקובלות. אלו בזרוע "VO" קיבלו 12 מחזורים של venetoclax (מעכב BCL2) עם קורס של obinutuzumab (נוגדן CD20) שהתווסף במהלך ששת המחזורים הראשונים. אלו ב"זרוע VI" קיבלו 12 מחזורים של venetoclax לאחר שלושה מחזורים של איברוטיניב.
בזמן הניתוח, תקופת המעקב החציונית הייתה 34 חודשים, עם טווח של אפס עד 49 חודשים. שיעורי ההישרדות ללא התקדמות היו 81% בזרוע I, 81.1% בזרוע VO ו-79.4% בזרוע VI. ההבדלים בין קבוצות ירדו מתחת לסף שנקבע מראש לאי-נחיתות, ועמדו בנקודת הסיום העיקרית של המחקר לנקודת זמן זו.
שלוש הזרועות גם הראו תוצאות דומות מבחינת התגובה הכוללת לטיפול והישרדות כוללת, עם שיעורי תגובה כלליים שנעו בין 84.2% ל-88.5% והישרדות כללית נעה בין 91.5% ל-96.0%.
לקבוצה שקיבלה טיפול מתמשך באיברוטיניב היה שיעור נמוך יותר של תגובה מלאה לטיפול, נקודת סיום שהושגה רק ב-8.3% מזרוע I בהשוואה ל-51.5% בזרוע VO ו-46.2% בזרוע VI. בנוסף, אף אחד מהחולים שקיבלו איברוטיניב מתמשך לא השיג את הסטטוס של מחלה שארית בלתי ניתנת למדידה (MRD), סמן ביולוגי המצביע על כך שכל או כמעט כל התאים הסרטניים חוסלו. לעומת זאת, MRD בלתי ניתן לזיהוי הושג ב-73% ו-62% מהחולים כפי שנמדדו בדם, ו-62% ו-40% מהחולים כפי שנמדדו במח העצם עבור זרועות VO ו-VI, בהתאמה.
"נקודות הקצה המשניות הן פרמטרים חלופיים עבורנו כדי להניח יעילות ארוכת טווח", אמר ד"ר אל סוואף. "עם פרדיגמת משך הזמן הקבוע, אנו רואים שיעורים גבוהים יותר של תגובה מלאה ותגובות MRD, ועם הטיפול המתמשך בסוכן יחיד אנו רואים תגובה מלאה ותגובות MRD נמוכות יותר."
שיעורי תופעות הלוואי היו דומים באופן כללי בכל זרועות המחקר, כאשר הבעיות הנפוצות ביותר היו זיהומים והפרעות במערכת העיכול. הפרעות בדם ובמערכת הלימפה, הפרעות לב וסוגי סרטן שניים היו גם שכיחים מעט בכל הזרועות.
ניתוחי תת-קבוצות הראו שבעיות קרדיווסקולריות היו שכיחות יותר בקרב חולים שקיבלו איברוטיניב, במיוחד בקרב אלו שנטלו איברוטיניב למשך זמן ארוך יותר. Obinutuzumab היה קשור לסיכון גבוה יותר לזיהומים חמורים ועם הישרדות קצרה יותר ללא התקדמות בקרב חולים עם צורות אגרסיביות של CLL.
החוקרים אמרו כי המעקב המתמשך במסגרת הניסוי יעזור לחזק את העדויות להבדלים בביצועים בין גישות הטיפול השונות. בנוסף, ד"ר אל סוואף אמר כי מחקרים אחרים נמצאים בעיצומם לאיתור סמנים ביולוגיים שעשויים לעזור לרופאים לקבוע אילו מטופלים צפויים להפיק תועלת מכל אסטרטגיית טיפול.
המחקר בוצע ביוזמת החוקר בחסות אוניברסיטת קלן; AbbVie Inc., Janssen Pharmaceuticals ו-Roche Pharmaceuticals סיפקו את תרופות המחקר ומימון כדי לתמוך בניהול הניסוי; חלקים מהניתוחים וצוות המחקר נתמכו על ידי קרן המחקר הגרמנית (Deutsche Forschungsgemeinschaft).
מחקר זה פורסם במקביל ב NEJM.
עותמאן אל סוואף, MD, מאוניברסיטת קלן, יציג את המחקר הזה ביום ראשון, 7 בדצמבר 2025, בשעה 14:05 שעון מזרח במהלך המושב המדעי במליאה באולם המערבי D2 של מרכז הכנסים של מחוז אורנג'.